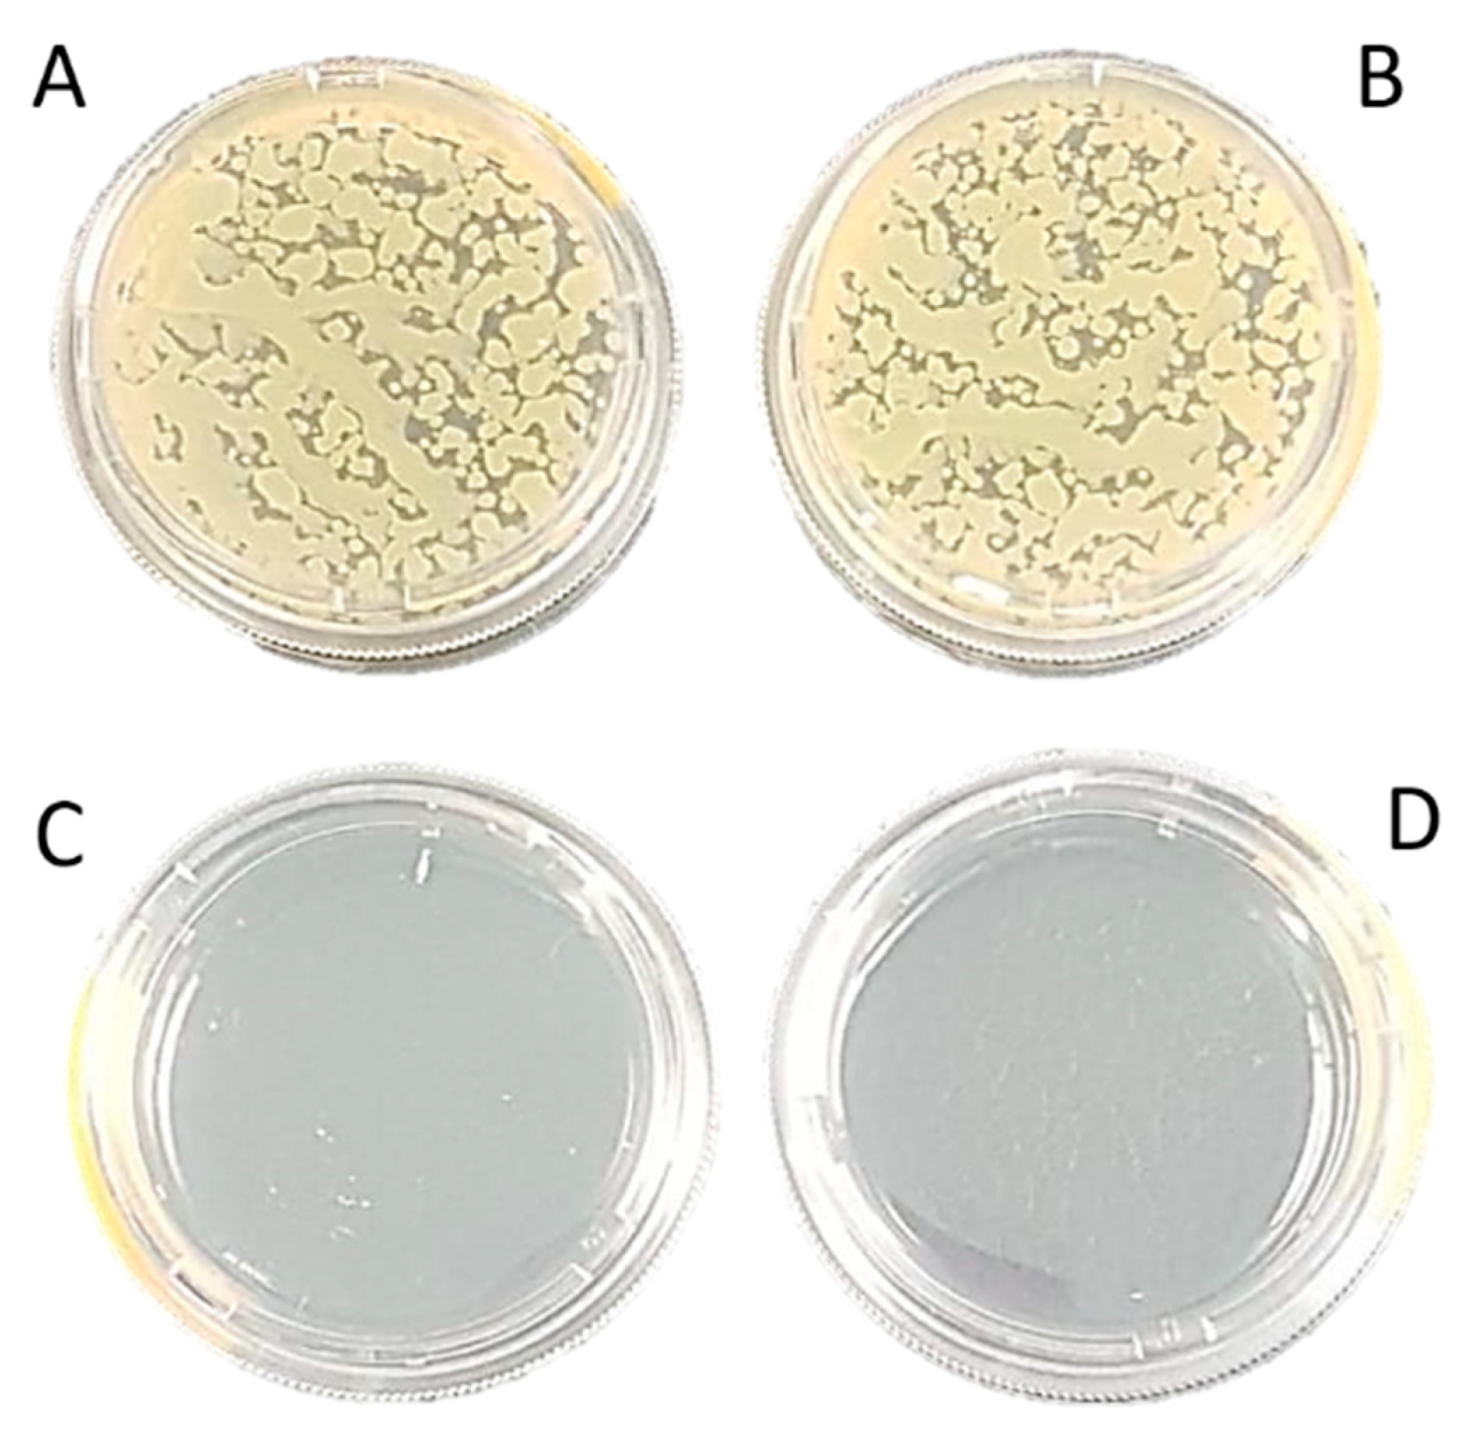
Nanomanufacturing 01 00006 g006

Effectiveness of Different Cellulose-Based Filtration Materials against Inhalation of SARS-CoV-2-Like Particles
Abstract
:1. Introduction
2. Materials and Methods
2.1. Filter Tested Materials
2.2. Filter Characterization
2.2.1. Retention Test, Time Saturation Test and Aerosol Penetration Test
2.2.2. Nanoparticle Filtration Test
2.2.3. Study of Filter Morphology
2.2.4. Bacterial Filtration Efficiency (BFE)
2.2.5. Filter Time-of-Use
2.2.6. Filter Usage Time
3. Results and Discussion
4. Conclusions
Author Contributions
Funding
Institutional Review Board Statement
Informed Consent Statement
Data Availability Statement
Acknowledgments
Conflicts of Interest
References
- Lancet, T. COVID-19: Protecting health-care workers. Lancet 2020, 395, 922. [Google Scholar] [CrossRef]
- Bourrous, S.; Barrault, M.; Mocho, V.; Poirier, S.; Ouf, F.-X.; Bardin-Monnier, N.; Charvet, A.; Thomas, D.; Bescond, A.; Fouqueau, A.; et al. A Performance Evaluation and Inter-laboratory Comparison of Community Face Coverings Media in the Context of COVID-19 Pandemic. Aerosol Air Qual. Res. 2021, 21. [Google Scholar] [CrossRef]
- Cook, T.M. Personal protective equipment during the COVID-19 pandemic—A narrative review. Anaesthesia 2020. [Google Scholar] [CrossRef] [Green Version]
- Fathizadeh, H.; Maroufi, P.; Momen-Heravi, M.; Dao, S.; Köse, Ş.; Ganbarov, K.; Pagliano, P.; Esposito, S.; Kafil, H.S. Protection and disinfection policies against SARS-CoV-2 (COVID-19). Infez. Med. 2020, 28, 185–191. [Google Scholar]
- Jayaweera, M.; Perera, H.; Gunawardana, B.; Manatunge, J. Transmission of COVID-19 virus by droplets and aerosols: A critical review on the unresolved dichotomy. Environ. Res. 2020, 188, 109819. [Google Scholar] [CrossRef] [PubMed]
- Bauchner, H.; Fontanarosa, P.B.; Livingston, E.H. Conserving Supply of Personal Protective Equipment—A Call for Ideas. JAMA 2020, 323, 1911. [Google Scholar] [CrossRef] [PubMed] [Green Version]
- Coia, J.E.; Ritchie, L.; Adisesh, A.; Makison Booth, C.; Bradley, C.; Bunyan, D.; Carson, G.; Fry, C.; Hoffman, P.; Jenkins, D.; et al. Guidance on the use of respiratory and facial protection equipment. J. Hosp. Infect. 2013, 85, 170–182. [Google Scholar] [CrossRef] [PubMed]
- Park, S.H. Personal Protective Equipment for Healthcare Workers during the COVID-19 Pandemic. Infect. Chemother. 2020, 52, 165–182. [Google Scholar] [CrossRef] [PubMed]
- European Centre for Disease Prevention and Control. Using Face Masks in the Community; European Union: Stockholm, Sweden, 2020. [Google Scholar]
- Balachandar, V.; Mahalaxmi, I.; Kaavya, J.; Vivekanandhan, G.; Ajithkumar, S.; Arul, N.; Singaravelu, G.; Senthil Kumar, N.; Mohana Dev, S. COVID-19: Emerging protective measures. Eur. Rev. Med. Pharmacol. Sci. 2020, 24, 3422–3425. [Google Scholar] [CrossRef]
- ANVISA. Resolução da Diretoria Colegiada (RDC) 356/2020. Available online: http://portal.anvisa.gov.br (accessed on 17 February 2021).
- Associação Brazileira de Normas Técnicas. Respiratory Protective Devices—Filtering Half Mask to Protect against Particles (ABNT NBR 13698:2011); Technical Norm, Zambini Institute; Associação Brazileira de Normas Técnicas: Rio de Janeiro, Brazil, 2011; ISBN 978-85-07-02692-1. [Google Scholar]
- Associação Brazileira de Normas Técnicas. Respiratory Protective Devices—Particle Filters (ABNT NBR 13697:2010); Technical Norm, Zambini Institute; Associação Brazileira de Normas Técnicas: Rio de Janeiro, Brazil, 2010; ISBN 978-85-07-02230-5. [Google Scholar]
- Lim, H.-R.; Kim, Y.-S.; Kwon, S.; Mahmood, M.; Kwon, Y.-T.; Lee, Y.; Lee, S.M.; Yeo, W.-H. Wireless, Flexible, Ion-Selective Electrode System for Selective and Repeatable Detection of Sodium. Sensors 2020, 20, 3297. [Google Scholar] [CrossRef]
- Zhu, N.; Zhang, D.; Wang, W.; Li, X.; Yang, B.; Song, J.; Zhao, X.; Huang, B.; Shi, W.; Lu, R.; et al. A Novel Coronavirus from Patients with Pneumonia in China, 2019. N. Engl. J. Med. 2020, 382, 727–733. [Google Scholar] [CrossRef] [PubMed]
- de Araujo, A.R.; Ramos-Jesus, J.; de Oliveira, T.M.; de Carvalho, A.M.A.; Nunes, P.H.M.; Daboit, T.C.; Carvalho, A.P.; Barroso, M.F.; de Almeida, M.P.; Plácido, A.; et al. Identification of Eschweilenol C in derivative of Terminalia fagifolia Mart. and green synthesis of bioactive and biocompatible silver nanoparticles. Ind. Crops Prod. 2019, 137, 52–65. [Google Scholar] [CrossRef]
- UNE-EN 14683:2019+AC:2019. Medical Face Masks—Requirements and Test Methods; UNE—Normalización Española: Madrid, Spain, 2019. [Google Scholar]
- Clinical Laboratory Standards Institute (CLSI). Methods for Dilution Antimicrobial Susceptibility Test for Bacteria That Grow Aerobically. Approved Standard M07–A10; CLSI: Wayne, PA, USA, 2015. [Google Scholar]
- Konda, A.; Prakash, A.; Moss, G.A.; Schmoldt, M.; Grant, G.D.; Guha, S. Aerosol Filtration Efficiency of Common Fabrics Used in Respiratory Cloth Masks. ACS Nano 2020, 14, 6339–6347. [Google Scholar] [CrossRef]
- Zangmeister, C.D.; Radney, J.G.; Vicenzi, E.P.; Weaver, J.L. Filtration Efficiencies of Nanoscale Aerosol by Cloth Mask Materials Used to Slow the Spread of SARS-CoV-2. ACS Nano 2020, 14, 9188–9200. [Google Scholar] [CrossRef]
- Thakur, V.K.; Thakur, M.K. Processing and characterization of natural cellulose fibers/thermoset polymer composites. Carbohydr. Polym. 2014, 109, 102–117. [Google Scholar] [CrossRef]
- Wang, J.; Tronville, P. Toward standardized test methods to determine the effectiveness of filtration media against airborne nanoparticles. J. Nanopart. Res. 2014, 16, 2417. [Google Scholar] [CrossRef] [Green Version]
- Balazy, A.; Toivola, M.; Reponen, T.; Podgórski, A.; Zimmer, A.; Grinshpun, S.A. Manikin-based performance evaluation of N95 filtering-facepiece respirators challenged with nanoparticles. Ann. Occup. Hyg. 2006, 50, 259–269. [Google Scholar] [CrossRef] [PubMed] [Green Version]
- Tiliket, G.; Sage, D.L.; Moules, V.; Rosa-Calatrava, M.; Lina, B.; Valleton, J.M.; Nguyen, Q.T.; Lebrun, L. A new material for airborne virus filtration. Chem. Eng. J. 2011, 173, 341–351. [Google Scholar] [CrossRef]
- Rengasamy, S.; Eimer, B.C.; Shaffer, R.E. Comparison of nanoparticle filtration performance of NIOSH-approved and CE-marked particulate filtering facepiece respirators. Ann. Occup. Hyg. 2009, 53, 117–128. [Google Scholar] [CrossRef]
- Praveena, S.M.; Han, L.S.; Than, L.T.L.; Aris, A.Z. Preparation and characterisation of silver nanoparticle coated on cellulose paper: Evaluation of their potential as antibacterial water filter. J. Exp. Nanosci. 2016, 11, 1307–1319. [Google Scholar] [CrossRef] [Green Version]
- Diniz, F.R.; Maia, R.C.A.P.; Rannier, L.; Andrade, L.N.; Chaud, M.V.; da Silva, C.F.; Corrêa, C.B.; de Albuquerque Junior, R.L.C.; da Costa, L.P.; Souto, E.B.; et al. Silver nanoparticles-composing alginate/gelatin hydrogel improves wound healing in vivo. Nanomaterials 2020, 10, 390. [Google Scholar] [CrossRef] [Green Version]
- Sánchez-López, E.; Gomes, D.; Esteruelas, G.; Bonilla, L.; Lopez-Machado, A.L.; Galindo, R.; Cano, A.; Espina, M.; Ettcheto, M.; Camins, A.; et al. Metal-Based Nanoparticles as Antimicrobial Agents: An Overview. Nanomaterials 2020, 10, 292. [Google Scholar] [CrossRef] [PubMed] [Green Version]
- Chen, W.; Abe, K.; Uetani, K.; Yu, H.; Liu, Y.; Yano, H. Individual cotton cellulose nanofibers: Pretreatment and fibrillation technique. Cellulose 2014, 21, 1517–1528. [Google Scholar] [CrossRef]
- Imai, M.; Furujo, A.; Sugiyama, J. Direct observation of cellulase penetration in oven-dried pulp by confocal laser scanning microscopy. Cellulose 2019, 26, 7653–7662. [Google Scholar] [CrossRef]
- Neupane, B.B.; Mainali, S.; Sharma, A.; Giri, B. Optical microscopic study of surface morphology and filtering efficiency of face masks. PeerJ 2019, 7, e7142. [Google Scholar] [CrossRef] [Green Version]
- Kumar, A.; Sangeetha, D.N.; Yuvaraj, R.; Menaka, M.; Subramanian, V.; Venkatraman, B. Quantitative Performance Analysis of Respiratory Facemasks Using Atmospheric and Laboratory Generated Aerosols Following with Gamma Sterilization. Aerosol Air Qual. Res. 2021, 21, 200349. [Google Scholar] [CrossRef]
- Kähler, C.J.; Hain, R. Fundamental protective mechanisms of face masks against droplet infections. J. Aerosol Sci. 2020, 148, 105617. [Google Scholar] [CrossRef]
- Jung, S.; An, J.; Na, H.; Kim, J. Surface Energy of Filtration Media Influencing the Filtration Performance against Solid Particles, Oily Aerosol, and Bacterial Aerosol. Polymers 2019, 11, 935. [Google Scholar] [CrossRef] [Green Version]

| Material | Total Retention (%) | Time of Saturation (s) |
|---|---|---|
| Qualitative paper filter | 99.0 | 16.0 |
| Cotton disc | 96.0 | 17.0 |
| Coffee filter | 98.6 | 7.0 |
| Surgical mask | 78.0 | 45.0 |
| N95 respirator | 98.5 | 70.0 |
Publisher’s Note: MDPI stays neutral with regard to jurisdictional claims in published maps and institutional affiliations. |
© 2021 by the authors. Licensee MDPI, Basel, Switzerland. This article is an open access article distributed under the terms and conditions of the Creative Commons Attribution (CC BY) license (https://creativecommons.org/licenses/by/4.0/).
Share and Cite
Araújo, A.R.d.; Nunes, L.C.C.; Oliveira, K.C.B.F.; Carvalho, M.G.F.M.; Cardoso, J.C.; Severino, P.; Soares, M.F.L.R.; Souto, E.B.; Lima, G.D. Effectiveness of Different Cellulose-Based Filtration Materials against Inhalation of SARS-CoV-2-Like Particles. Nanomanufacturing 2021, 1, 57-66. https://doi.org/10.3390/nanomanufacturing1020006
Araújo ARd, Nunes LCC, Oliveira KCBF, Carvalho MGFM, Cardoso JC, Severino P, Soares MFLR, Souto EB, Lima GD. Effectiveness of Different Cellulose-Based Filtration Materials against Inhalation of SARS-CoV-2-Like Particles. Nanomanufacturing. 2021; 1(2):57-66. https://doi.org/10.3390/nanomanufacturing1020006
Chicago/Turabian StyleAraújo, Alyne R. de, Lívio C. C. Nunes, Karla C. B. F. Oliveira, Maria G. F. M. Carvalho, Juliana C. Cardoso, Patricia Severino, Monica F. L. R. Soares, Eliana B. Souto, and Gildário D. Lima. 2021. "Effectiveness of Different Cellulose-Based Filtration Materials against Inhalation of SARS-CoV-2-Like Particles" Nanomanufacturing 1, no. 2: 57-66. https://doi.org/10.3390/nanomanufacturing1020006
APA StyleAraújo, A. R. d., Nunes, L. C. C., Oliveira, K. C. B. F., Carvalho, M. G. F. M., Cardoso, J. C., Severino, P., Soares, M. F. L. R., Souto, E. B., & Lima, G. D. (2021). Effectiveness of Different Cellulose-Based Filtration Materials against Inhalation of SARS-CoV-2-Like Particles. Nanomanufacturing, 1(2), 57-66. https://doi.org/10.3390/nanomanufacturing1020006

